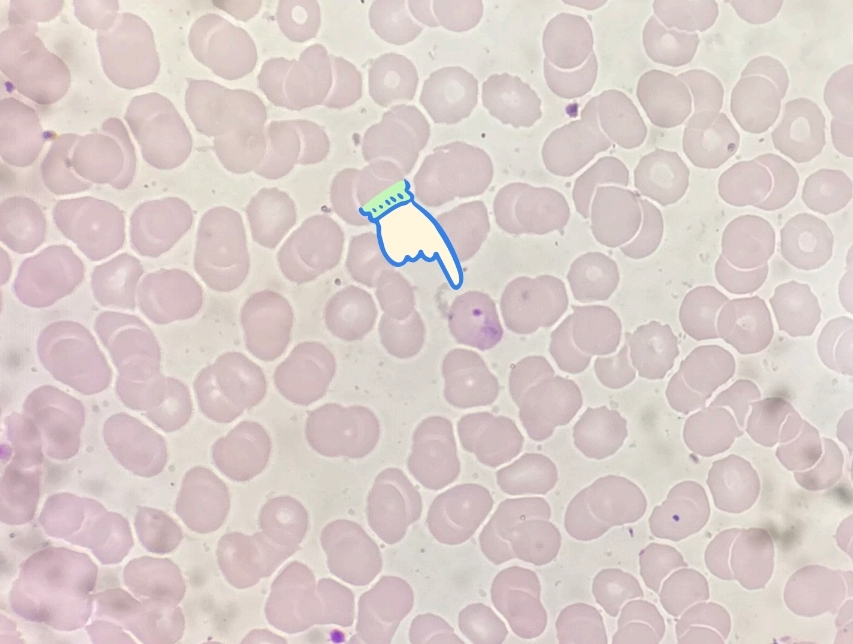
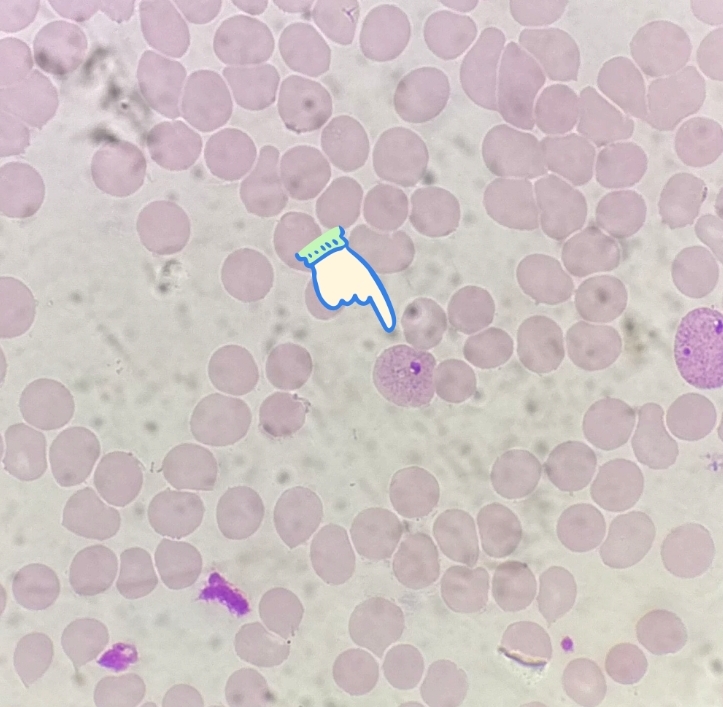
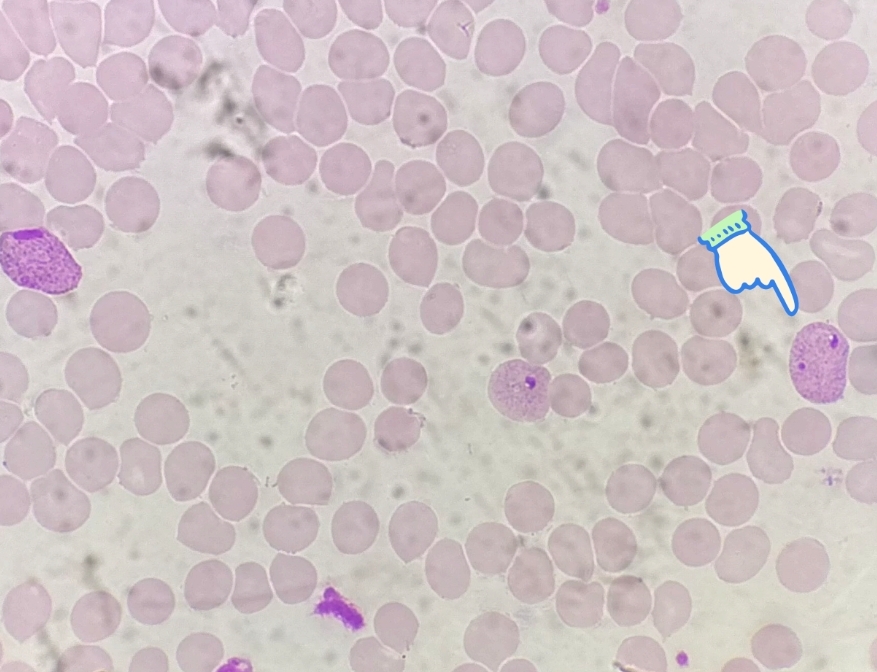
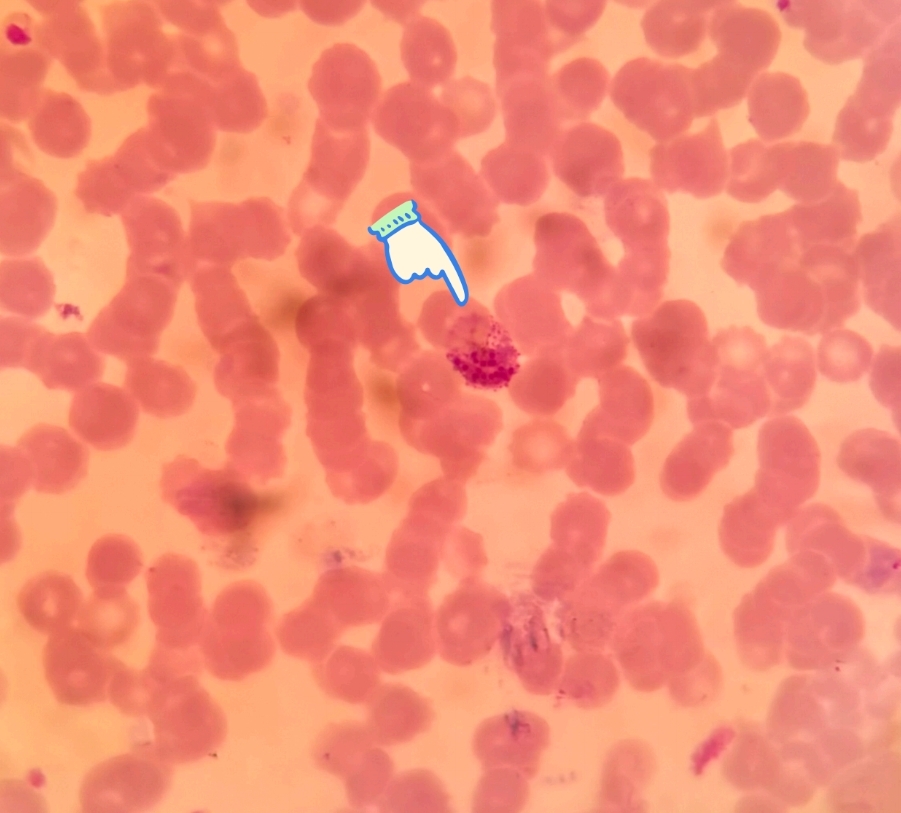
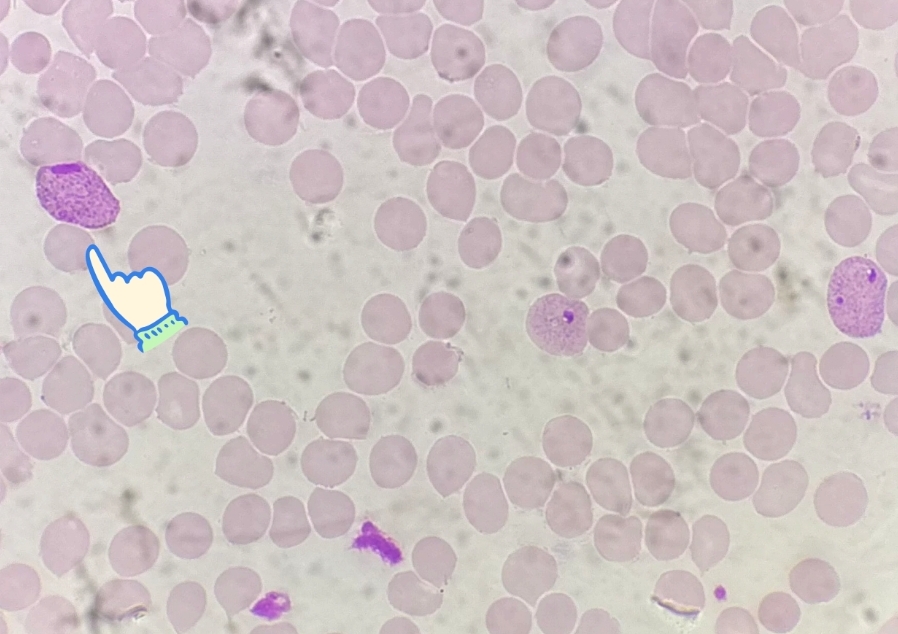
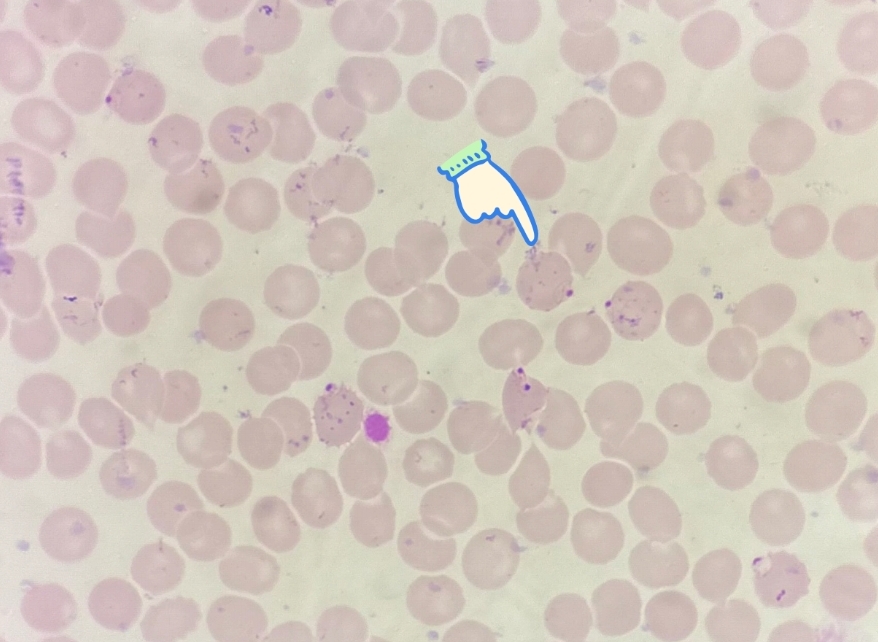
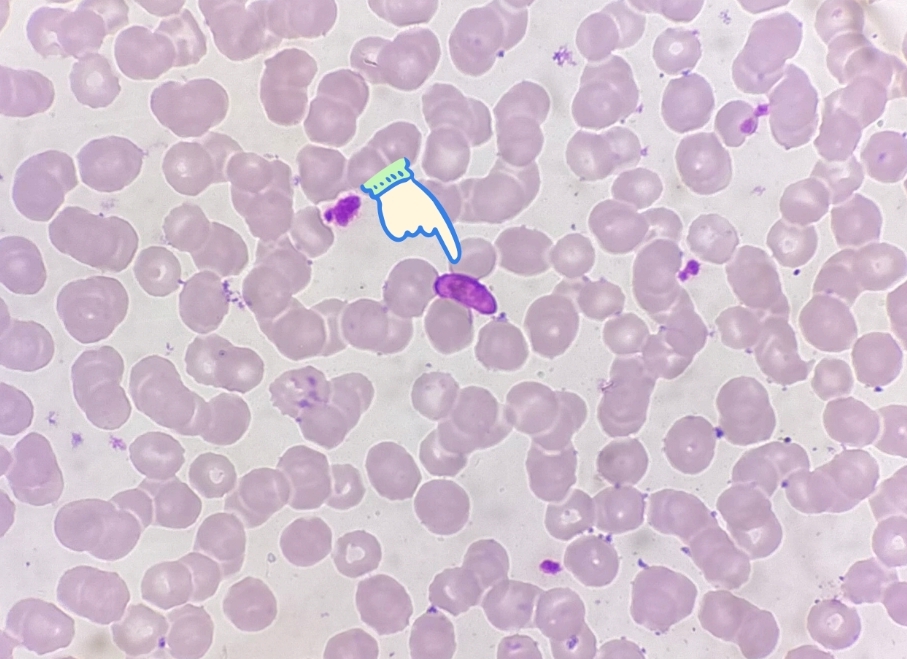
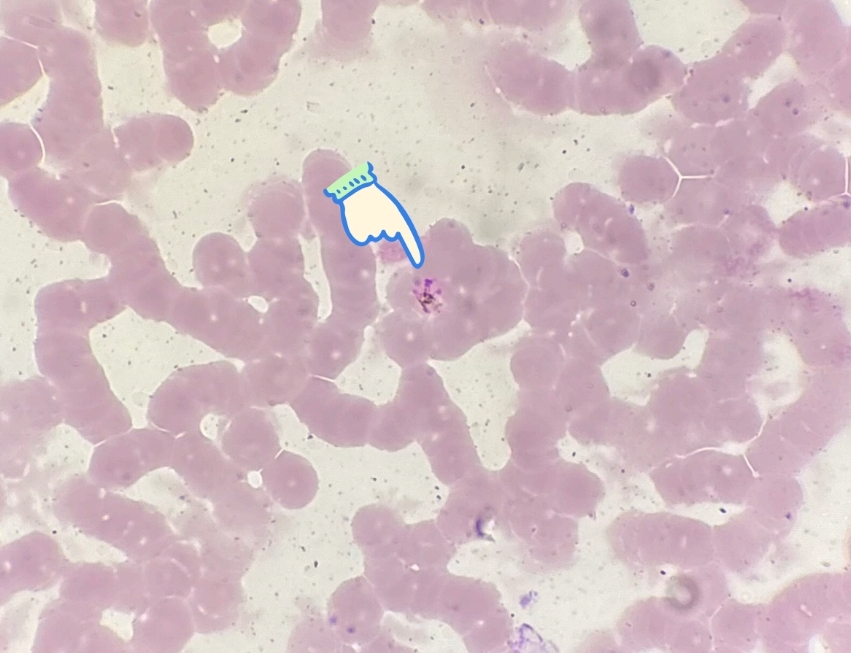

Parasitologi Plasmodium & Arthropoda
1/41
There's no tags or description
Looks like no tags are added yet.
Name | Mastery | Learn | Test | Matching | Spaced |
|---|
No study sessions yet.
42 Terms
apa ini?
Plasmodium vivax (Trofozoit muda)
apa ini?
Plasmodium vivax (trofozoit tua)
apa ini?
Plasmodium vivax (Skizon muda)
apa ini ?
Plasmodium vivax (skizon tua)
apa ini?
Plasmodium vivax (Makrogametosit)

apa ini?
Plasmodium vivax (Apusan darah tebal)
apa ini?
Plasmodium Falciparum (Trofozoit muda)
apa ini?
Plasmodium falciparum (Mikrogametosit)

apa ini?
Plasmodium falciparum (Makrogametosit)

apa ini?
Plasmodium falciparum (apusan darah tebal)

apa ini?
Plasmodium malariae (Trofozoit muda)

apa ini?
Plasmodium malariae (trofozoit tua)
apa ini?
Plasmodium malariae (skizon tua)

apa ini?
Plasmodium malariae (Makrogametosit)

apa ini?
Plasmodium malariae (mikrogametosit)

apa ini?
Anopheles (Telur)

apa ini?
Anopheles (Larva)

apa ini?
Anopheles (pupa)

apa ini ?
Anopheles (Nyamuk dewasa jantan)

apa ini?
Culicini (pupa)

apa ini?
Culex (Telur)

apa ini?
Culex (Larva)

apa ini?
Culex (nyamuk dewasa jantan)

apa ini
Anopheles (Betina)

apa ini?
Culex (Betina)

apa ini ?
Aedes (telur)

apa ini?
Aedes Aegypty (Larva)

apa?
Aedes (Nyamuk Dewasa Betina)

apa ini ?
Aedes Albopictus (Jantan)

apa ini?
Aedes Aegypti (Dewasa Betina)

apa ini?
Mansonia (Telur)

Apa ini?
Culicoides

apa ini?
Cimex Hemipterus (Jantan)

apa ini?
Cimex Hemipterus (Jantan)

apa ini?
Ctenocephalides Felis (Jantan)

apa ini?
Ctenocephalides felis (Betina)

apa ini?
Xenopsyllah cheopis (Betina)

apa ini
Pediculus Humanus Capitis (jantan)

apa ini?
Pediculus humanus corporis (jantan)

apa ini?
Phitirus pubis (betina)

apa ini?
Sarcoptes scabiei

apa ini?
Cyclops (betina)